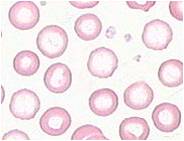

Beda Hasil Lab Thalassemia & Defisiensi Fe
Terkadang penderita thalassemia, terutama yang ringan (thalassemia beta trait), sering salah terdiagnosa sebagai anemia defisiensi Fe. Hal ini dikarenakan gejala yang dialami penderita dan gambaran laboratorium, terutama hapusan darah yang hampir sama.
Berbeda dengan thalassemia mayor dengan gejala yang muncul anemia berat sampai facies mongoloid dan gambaran hapusan darah yang sangat bervariasi, pada thalassemia trait, gejala yang timbul kebanyakan hanya berupa anemia ringan dengan gambaran hapusan darah hipokrom mikrositik. Sehingga seringkali kita kesulitan membedakan dan terkadang misdiagnosa.
Untuk meminimalisir kesalahan tersebut, ada sedikit perbedaan yang perlu kita ketahui :
1. kita lihat bagaimana hasil serum iron, TIBC, dan ferritin. Pada thalassemia trait hasil ketiga lab tersebut normal, sedangkan pada anemia defisiensi Fe serum iron dan ferritin mengalami penurunan dan TIBC naik.
2. Dihitung berapakah Mentzer Indexnya. Didapat dari pembagian MCV dengan jumlah eritrosit (MCV/RBC). Apabila hasilnya >13 berarti anemia defisiensi Fe, sedangkan bila <13 berarti thalassemia beta trait.
Semoga bermanfaat.
sumber : Manual Clinical of Hematology

![[Download] Pedoman Nasional Pelayanan Kedokteran Tata Laksana Thalassemia (KMK)](/content/images/uploads/2022/10/KMK.jpg)
![[Download] Pemeriksaan Laboratorium pada Thalassemia](/content/images/uploads/2022/09/cover-web-scaled.jpg)